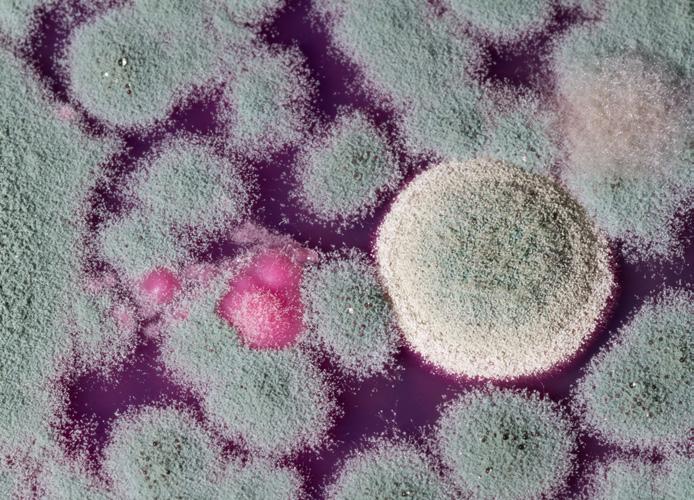

![]()



Ready to use highly efficient disinfecting mould cleaner with multiple uses and application methods. Suitable for light, medium and severely contaminated surfaces.




A single product with countless possible applications!
FAST EFFECTIVE RELIABLE


READY-TO-USE – FOAMABLE SOLUTION FOR MOULD CLEANING AND SURFACE DISINFECTION


A PRODUCT FOR A WIDE RANGE OF APPLICATIONS IN PROFESSIONAL DAMAGE RESTORATION
An innovative disinfectant specifically developed for the effective removal of mould. Thanks to its special formula, SD7 is also suitable for numerous other cleaning and disinfection tasks for professional damage restoration services.
Sanosil SD7 offers everything you need – without compromising on quality, safety, results, or cost-effectiveness. Why use anything else when SD7 offers you everything and more?

SD7 stands for brilliant simplicity that every damage restoration technician will appreciate in their daily work.
This brochure shows you how to unlock the full potential of SD7.


The new Sanosil SD7 disinfectant cleaner with hydrogen peroxide (H2O2) was developed using state-art-the-art technology. SD7 was primarily developed as a disinfectant for mould removal in the damage restoration industry. The main objective with SD7 was to develop a user-friendly disinfectant with highly effective cleaning capabilities and strong disinfection power.
Sanosil SD7 consists of a 7.9% H2O2 ready to use solution with a specially formulated surfactant package boosting the cleaning power of SD7. SD7 can tackle both mild and severe mould-growth and is very pleasant to work with.

Excellent wetting effect on all surfaces – the products ability to penetrate semi-porous to porous surfaces like wooden constructions, concrete, plaster and more to deep-clean, loosen and inactivate and remove mould including its roots, is unique to this product. The low surface tension of SD7 allows the product to efficiently, via capillary action, to pull itself into joints and cracks i.e. wooden constructions and more.
SD7 foams profusely (like Serum 1000) on contact with the mould enzymes showing the user where the living mould is present.
Thanks to the advanced surfactants, SD7's cleaning performance is extremely good.
SD7 can be applied as liquid but also as a foam which makes SD7 stick to surfaces for longer contact times and improved cleaning capabilities.
When you apply SD7 as a foam, you do NOT create any aerosols, which is nice and safe for the user. Surface foam is created with a special foam sprayer. We have at NAC several foam sprayers in our product portfolio.
SD7 can be mixed with our new liquid SFS polymer/resin agent to spray as a thick foam into inaccessible cavities/confined spaces to inactivate mould and fix (bind) the inactivated mould spores to the surface. The SD7/SFS foam is very stable and thick, but still has the ability to fill cracks and joints in cavities/confined spaces. The thick and stable foam is being produced by a special foamsprayer, see details in this brochure.
SD7 can also be used efficiently in a ULV cold-fogger for disinfection in larger rooms
And there are many more nice features about this product.
Sanosil SD7 is a ready-to-use, next-generation mould control agent. It is formulated with enhanced hydrogen peroxide and boasts excellent wetting properties. This allows for rapid and deep penetration, even into dense mould structures. When combined with suitable foam sprayers, Sanosil SD7 can be foamed, enabling low-aerosol application and optimized surface coverage.
Low-odour hydrogen peroxide is used as the active ingredient, which is further stabilized and its disinfectant effect is greatly enhanced by the addition of surfactants. These substances have a synergistic effect and combine with the hydrogen peroxide to form a highly effective biocidal mixture. This combination significantly increases the disinfecting effect of the hydrogen peroxide.
After application, the active ingredient, hydrogen peroxide, completely decomposes into water and oxygen. No flammable or unpleasant smelling vapours are released. This makes it safe to use in living rooms and bedrooms.
EFFECTIVE AGAINST MOULD TOXINS
Moulds can affect health not only due to the allergy-inducing surface proteins on the mycelia and spores, but potentially also through the formation of strong toxins. These mycotoxins are relatively stable and can enter the body through food as well as through the air.
SD7 also denatures the allergenic surface proteins on mould components. This provides Sanosil SD7 with a special advantage in terms of its effectiveness and makes it superior to many other products.
Product type Ready to use.
Suitable for Mould control, disinfecting water damage.
Effective aggainst
Bacteria, yeasts, fungi, viruses (enveloped, including coronaviruses, influenza and noroviruses = limited virucidal activity PLUS).
Shelf life 2 years
7.8% hydrogen peroxide
Contains
0.5% phenoxyethanol < 1% anionic and non-ionic surfactants


2 1
1
The oxygen released by hydrogen peroxide (1O2 /- O2) attacks the cell walls of microorganisms. Through oxidation (cold combustion), the cell walls are denatured and destroyed.
The effect is supported by complexing agents and surfactants, which bind calcium ions while also masking metal ions. This severely weakens the surfaces of the microorganisms and makes them highly susceptible to the oxidizing effect of hydrogen peroxide. 2

Practically odourless – ideal for surface disinfection and controlling mould. ...fast-acting and versatile.

Fast-acting against mould fungi/spores, bacteria, yeast and enveloped viruses (including coronaviruses, influenza and noroviruses).
Tested in accordance with EN test standards with high organic loads.
Has an oxidative effect on many mould toxins and allergenic proteins.
Foamable for optimised surface coverage and reduced aerosol formation.
Excellent wetting effect on all surfaces.
Does not cause unpleasant odours.
With synergistically enhanced hydrogen peroxide.
The hydrogen peroxide completely (100%) decomposes into water and oxygen.
Shelf life of over 2 years.
High-quality product, manufactured under ISO 13485 Medical Standard in Switzerland.
Even the best mildew remover cannot guarantee lasting success without eliminating the cause of the infestation. Mould spores need moisture to grow. The cause of an increased presence of moisture must therefore be determined and remedied.
The two most common causes of mould growth in buildings are A excessive humidity (usually in combination with insulation deficiencies, which then leads to the wi-despread "grey corners") and B furniture positioned too close to the outside walls.
If there is a relative humidity over 65% – measured 1 m above the floor in the middle of the room at a room temperature of 20°C in autumn/winter – there is a risk of mould due to condensation.
If the surface temperature in a poorly insulated corner, for example, drops below 13°C under "normal" conditions (20°C, 60-65% relative humidity), condensation can cause mould to form.
Large items of furniture, such as cupboards etc. that are placed against an external wall, should be placed at a distance of 10-15 cm (one fist width) from the wall.
EFFECTIVENESS STANDARDS / EXPOSURE TIMES
EN 13727, high load: 5 min
Bacteria (bactericidal))
Yeast (levurocidal))
Fungi
Viruses
Spores (clostridium difficile)
Good to know:
EN 17387, high load: 5 min
EN 17387, high load: 3 min
EN 13624, high load: 5 min EN 17387: 5 min
EN 13624, high load: 15 min
EN 17387, high load: 5 min
Limited virucidal activity PLUS: EN 14476, high load: 5 min
EN 17126, low load: 60 min
Limited virucide = Effective against enveloped viruses (e.g. influenza, coronavirus, HIV, Ebola)
Limited virucidal activity PLUS = Effective against enveloped viruses + adenoviruses and noroviruses


WHERE CAN I USE SD7 AGAINST MOULD AND HOW DO I USE IT CORRECTLY?
User guide for mould remediation.
Cleaning in indoor environments of mould, bacteria etc.
Sanosil SD7 is a ready-to-use cleaning and disinfecting agent with exceptional effectiveness against mould and other microorganisms. It is based on the proven Sanosil hydrogen peroxide formulation and releases no flammable or malodorous fumes. Sanosil SD7 is odour neutral.
SD7 is suitable for use with high microbiological loads and increased requirements. The fast and reliable effectiveness against moulds combined with simple and safe handling has been repeatedly tested and confirmed under laboratory conditions and in practice. Sanosil SD7 breaks down completely into water and oxygen after use. This means that the SD7 can also be used in sensitive areas such as bedrooms and children’s rooms.
SD7 can be applied as a liquid, but also as a foam using NAC's efficient foam sprayers.


1. Longer contact times.
2. Optimal surface coverage.
3. Low-aerosol application.
4. Adhesion to vertical surfaces.
5. Improved cleaning performance.
6. Reduced chemical (SD7) consumption.
7. Optical marking with foam –ensures complete treatment of the entire surface.


WHERE CAN I USE SD7 AGAINST MOULD AND HOW DO I USE IT CORRECTLY?
Material / Surface Note!
Wallpapered surfaces with loose/slight mould growth on the upper side.
Wallpapered surfaces with mould growth on the back of the wallpaper and/or on the substrate.
Fibreglass wallpaper with a painted surface with mould growth on the surface.
Fibreglass wallpaper with a painted surface with mould growth on the back of the wallpaper/felt and/or on the substrate.
Other painted / varnished surfaces with mould growth on the surface.
Plaster layer with mould growth on the surface.
Plaster layer with mould growth in depth
Concrete walls without wallpaper, felt and the like.
Concrete floors without flooring and glue/adhesive.
Aerated concrete – inside.
Masonry – inside.
Roof tiles – the underside of underlined roof tiles.
Boards – roof structures.
Plywood – roof structures.
Solid wood – structural beams/rafters.
Solid wood – constructions in glulam/CLT.
Solid wood – floorboards.
OSB, MDF, plywood where the materials are not used in roof constructions.
Plasterboards
The wallpaper must have a good structure and stick to the wall. If not, remove the wallpaper and apply SD7 on the substrate.
Remove wallpaper and apply SD7 to the substrate.
Remove the wallpaper/felt and apply SD7 to the substrate.
Paint and varnish are organically based and can form a breeding ground for mould. Check whether the paint/varnish is intact and that it is only a matter of light/loose surface mould. If this is the case use SD7. If the paint/varnish is heavily attacked by mould and the structure is destroyed, remove the paint/varnish and apply SD7 to the substrate.
Remove all visible mould-contaminated plaster and apply SD7 to the substrate.
Before any cleaning/disinfection with Sanosil SD7, you must assess whether the mould attack has penetrated so deeply into materials such as e.g. plaster and woodwork, that the integrity and structure of the material is destroyed. If this is the case, the material should be discarded and replaced with new.
Sanosil SD7 should only be used as the only cleaning method if it is estimated that the mould attack is superficial.
If it is considered that the mould attack is deeper, a cleaning with Sanosil SD7 can be combined, if necessary, with a Serum 1000 cleaning or mechanical cleaning, such as e.g. planing, grinding/ milling or media/sandblasting, etc.
COVERAGE:
1 litre: 15-20 m2 on light mould attacks.
1 litre: 7-10 m2 on moderate-severe mould attack.
1. Prior to any treatment with Sanosil SD7, the cause of the mould growth should be located and found. To control mould, you must control the moisture. The cause of mould growth is usually elevated moisture values. Locate the cause and, if possible, ensure that it is rectified.
2. When remediating mould on woodwork/wooden structures, bring the moisture percentage below approx. 15%.
3. Ensure the safety of the building’s occupants and avoid cross-contamination of mould spores from dirty work areas to clean inhabited areas by enclosing the work area with dust walls, e.g. Zipwall. If possible or if necessary, establish underpressure or overpressure using HEPA air cleaners, axial or radial fans, etc.
4. Clean the work area before starting chemical treatment with Sanosil SD7. Remove the infested construction waste, insulation, masonry and concrete remains, etc. Sweep and vacuum the area with an industrial vacuum cleaner.
5. Mould remediation should be carried out as the last step in a remediation process in mould-affected areas.
Carry out your own quality control continuously during your remediation work with PRO-Clean rapid protein test or SystemSure Plus luminometer with UltraSnap surface ATP test.
Sanosil SD7 is ready to use and does not need to be diluted.
1. The surface must be vacuumed thoroughly with a HEPA vacuum cleaner to remove loose mould.
2. Pour Sanosil SD7 into a 5 or 1.25 liter quality pressure sprayer, e.g. NAC Sanosil pressure sprayer. When treating larger areas, it is recommended to use NAC’s electric magnetic pump sprayers, Power Sprayers.
3. Spray the mould infested area generously with SD7 which immediately reacts with the mould by producing a white foam. Let the SD7 work for 1-2 minutes.
4. Loose surface mould will boil up in the foam. Underlying mould stains (bio-film) will gradually dissolve in this process.
5. Scrub/treat all surfaces thoroughly with a nylon floor scrubber or nylon hand brush until the mould infestation is visibly loosened from the surface.
6. Wait at least 20 min. and then reapply SD7 to the areas that foamed. Repeat the process until it no longer foams.
7. When all areas have stopped foaming, wait until the surfaces are dry. Set up any dehumidifier to speed up drying of the area.
8. When the area is dry, HEPA vacuum EVERY cm2 very thoroughly to remove spores/fungal biomass. Smooth non-porous surfaces can also be cleaned of spores/fungal biomass with special microfiber cloths.
9. Own quality control. If necessary, check the cleanliness of the surface with PRO-Clean rapid test (rapid protein residue test) or SystemSure Plus luminometer with UltraSnap (surface ATP test) or similar. If the test is positive, repeat cleaning.
10. Continue to keep the area contained and protect the mould-remedied area from outside sources of contamination. Continue to use HEPA air purifiers, etc.
11. External control can be carried out after approx. 24 hours.
Ideal for mould treatment on hard-to-reach surfaces, cavities, intermediate spaces, niches, etc.




Mixed with the disinfectant Sanosil SD7, SFS forms a rich, fine-pored and biocidecontaining foam when used in suitable foam sprayers.
The SD7-SFS mixture is applied with a foam sprayer on hard-to-reach surfaces or sprayed into cavities/gaps, etc., where the mixture is transformed into a rich disinfecting foam that fills the entire cavity and inactivates the hard-to-reach mould material.
Fixes dead mould components on the surfaces so they don’t become airborne.
Effective against mould toxins and allergenic proteins by means of oxidation*.
Highly effective* against bacteria, viruses, yeasts, fungi/moulds and spores.
The hydrogen peroxide completely (100%) decomposes into water and oxygen*.
Does not cause unpleasant odours.
ONo alcohol, chlorine/chlorine compounds or QAV.
High-quality product made in Switzerland.
* mixed with Sanosil SD7 disinfectant.
The Sanosil SFS system is an alternative for mould remediation in places where it is not possible to use the HEPA sandwich method to remove the mould material, due to lack of access or limited space.
Sanosil SFS is a powerful foaming surfactant concentrate with modified acrylic resins for delayed film formation. It forms a biocidal active foam solution when applied together with the disinfectant Sanosil SD7. Bacteria and mould are killed during the liquid phase. Once the foam has dried, a film forms which traps dead mould spores and mycelium com-ponents and fixes them on the surface. This means that no more spores or mould components can enter the room air.
The classic mould removal method, the HEPA Sandwich Method, consists of: 1. thorough HEPA vacuuming; 2. chemical or mechanical removal of mould (or both methods in combination); 3. final thorough HEPA vacuuming of remaining mould material.
For technical and economic reasons, it is sometimes not possible to optimally implement the classic method of mould control (mechanically removing the dead biomass and inactivating the mould). For example, in the case of mould infestation on/in angled surfaces or cavities.
The solution of Sanosil SFS and Sanosil SD7, foamed using a suitable foaming device, is sprayed onto the infested surfaces or pressed into cavities. The biocidal agents eliminate mould components, spores and bacteria. In addition, mould toxins and proteins that trigger allergies as well as MVOCs
Product type
Suitable for
Dosing/mixing with Sanosil SD7
Biocidal effect of the active foam at 20°C
Consumption
Concentrate
Disinfection and fixation of mould in areas that are impossible to reach.
1 part by volume SFS and 2 parts by volume Sanosil SD7 disinfectant.
Fungi/moulds/yeasts: 15 min
Bacteria 15 min
Viruses: 30 min
Bacterial endospores: 60 min
100-150 ml foaming solution/ m2 = 30–50 ml SFS/m2
Shelf life 4 years
Contains
Anionic surfactants, modified acrylic resins, fragrance, preservative.
(which are responsible for musty smells) are eliminated/broken down by oxidation.
The dead biomass is encapsulated and fixed to the surfaces by the resin film that forms as the foam begins to dry. This effectively prevents it swirling up due to subsequent air currents and impact sounds from footsteps, etc.
Mould infestation with spore release.
Biocidal active foam encapsulates and inactivates moulds. Dead mould components are encapsulated and fixed in place.
The classic and always recommended method for mould removal (the HEPA Sandwich Method), where you:
1. First, thorough HEPA vacuuming of the affected surfaces for loose mould material.
2. Chemical cleaning or mechanical processing of the surface or a combination of these two methods.
3. Finally, VERY careful HEPA vacuuming of remaining inactivated mould material.
However, the HEPA Sandwich Method cannot always be used for technical and economic reasons. Eg. for hard-to-reach surfaces, cavities, etc.


The reasons can be:
1. Cavities under floors which rest on joists/beams or are otherwise raised.
2. Cavities in intermediate walls.
3. Hard-to-reach places due to mould in crawlspaces and attics etc.
In such cases, and in all other hard-to-reach places with limited space, a treatment with biocide-containing active foam can be a good alternative. This is because the mould material is treated/inactivated with the biocide product Sanosil SD7, and is encapsulated and fixed (sealed) on the surfaces by a breathable modified acrylic resin film which forms during drying. This means that mould material can no longer be released into the air. Prior to such treatment, it is of course assumed that the cause of the mould growth has been resolved.


The foam collapses and forms a sealing film. The remaining moisture must then be dried out.



The combination of SD7 with Sanosil SFS is ideal for controlling mould in cavities that are difficult to access. SFS is an additive that significantly increases the foamability of SD7 and makes a firmer, more stable foam possible. This can be pressed into mould-infested cavities and crevices, allowing disinfection there too. The dead biomass is fixed to the surface as the foam dries.
Identify and eliminate the cause of mould (e.g. leaking drainpipe). Otherwise, mould may start to grow again after a while.
Mix 1 part Sanosil SFS with 3 parts Sanosil SD7 and pour the solution into a foaming device. For the best results, a professional foaming device with a compressed air connection or an additional compressor with 6 bar/150 l of air output/min is required. Our recommendation: Birchmeier Indu-Matic 20M. This device produces a stable, fine creamy foam.



50 ml of SFS combined with 150 ml of Sanosil SD7 forms 200 ml of foam concentrate, which can be foamed to 25 to 50 times the volume (5,000 –10,000 ml). Cavities can thus be completely filled with disinfectant foam through holes (which may need to be drilled first). If necessary, a flexible PVC hose can be attached to the lance nozzle (using a suitable clamp), which can be moved in the cavity and simplifies foam distribution.
After the foam has been applied, wait for the foam to break down and for the film to form after drying. The exposure time depends on the situation, but should be several hours, or preferably overnight. Any remaining moisture can then be removed by blowing in warm drying air.


Any openings made to the foamed cavities for inserting the foam should not be closed again until it has been ensured that all residual moisture has dried out and the cause attributed to the mould growth has been completely eliminated.

Important: Always wear protective equipment (eyes and skin protection, P3 dust mask) during mould remediation work and when handling Sanosil SD7. Avoid skin and eye contact with SD7 or mould components.
Identify and eliminate the cause of mould (e.g. uninsulated roof substructure with moist air rising from the living area). Otherwise, mould may start to grow again after a while.
Mix 1 part Sanosil SFS with 2-3 parts Sanosil SD7 and pour the solution into a foaming device. For the best results, a professional foaming device with a compressed air connection or an additional compressor with 6 bar/150 l of air output/min is required. Our recommendation: Birchmeier Indu-Matic 20M. This device produces a stable, fine creamy foam.



Mix 40–50 ml of Sanosil SFS and 100 ml of Sanosil SD07 per m2 of surface and fill it into the foaming device. Wear protective equipment (for the skin/eyes). Connect the compressed air hose, select a relatively light foam setting and foam at 3.5 – 4 bar pressure using the flat spray nozzle. Wear suitable respiratory protection (min. P3) to protect yourself from aerosol formation. Foaming a surface with an area of 1 m2 takes approximately 20 seconds.
After the foam has been applied, wait for the foam to break down and for the film to form after drying. In case of enclosed rooms with poor air circulation, install a drying device to support the drying process as necessary.
This is what you need for the SFS





Verursacht durch Hochwasser, Wasserrohrbrüche oder blockierte Abwasserleitungen kann es zu Wassereintritten in Gebäuden kommen. In ungünstigen Fällen z.B. bei blockierten oder verstopften Abwasserleitungen oder bei Hochwasser kommt es zu Rückstauungen in der Kanalisation. In der Folge dringt Schmutzwasser, gemischt mit Abwasser in das Gebäude ein. Der mit Fäkal- und anderen Keimen verseuchte Schlamm dringt in jede Ritze und setzt sich dort fest. Besonders unangenehm ist dabei, wenn Abwasser in Unterlagsboden - bzw. Estrichkonstruktionen eindringt.
Flooding, burst water pipes, or blocked sewers can cause water ingress into buildings. In unfortunate cases, such as blocked or clogged sewers or flooding, the sewer system can back up. As a result, dirty water mixed with wastewater enters the building. The sludge, contaminated with fecal matter and other germs, penetrates every crack and becomes trapped there. This is especially troublesome when wastewater penetrates subfloors or screeds.
Abgesehen von direkten Schäden durch das eingedrungene Wasser wie Aufquellen von Holz/Sperrholzmaterialien, der Zerstörung von Geräten sowie einer allfälligen Geruchsbelästigung, sorgen die verteilten Keime für ein erhöhtes Infektionsrisiko. Zudem herrscht bei nicht sofortiger fachgerechter Trocknung die akute Gefahr von Schimmelpilzbildung.
SD7 : FOR LIMITED WATER DAMAGE
Aside from the direct damage caused by water penetration, such as swelling of wood/plywood materials, destruction of equipment, and potential unpleasant odors, the spread of germs poses an increased risk of infection. Furthermore, if the area is not dried properly and immediately, there is an acute risk of mould growth.






der Kanalisation. In der Folge dringt Schmutzwasser, bäude ein. Der mit Fäkal- und anderen Keimen und setzt sich dort fest. Besonders unangenehm boden - bzw. Estrichkonstruktionen eindringt.
Abgesehen von direkten Schäden durch das Holz/Sperrholzmaterialien, der Zerstörung von lästigung, sorgen die verteilten Keime für ein bei nicht sofortiger fachgerechter Trocknung die



Wasserschaden mit Fäkalwasser Toilette, Zwischenboden geflutet







Expose the water-damaged area as thoroughly as possible and make it accessible for disinfection.


If necessary, remove and dispose of any waterlogged and damaged materials such as swollen wood, insulation, cardboard, etc.
Wasserschaden mit Fäkalwasser Toilette, Zwischenboden geflutet
Completely pump/vacuum out the water and, if necessary, remove as much mud and dirt as possible from the surfaces. Caution: Ordinary wet vacuums without a filter system produce aerosols that can contain large quantities of germs. Wear a protective mask and eye protection!


Spray contaminated areas with SD7. Dosage approx. 50 ml per m². The disinfectant must remain in contact with the surface for at least 60 minutes. For heavily saturated materials, increase the amount of disinfectant applied to prevent dilution and thus a reduction in effectiveness.
Wasserschaden mit Schimmelbildung, Kellerraum nach Hochwasser
Remove dead mould spores with water and detergent. Remove and dispose of any remaining material that is heav ily infested with mould, waterlogged, or rotten.


After cleaning, perform a second disinfection with Sanosil SD7.
Initiation of drying measures until the building structure is completely dry.

Bakterien:
Wasserschaden mit Schimmelbildung in Zwischenboden (Holz)
Subsequently, restoration of materials damaged and/or removed by water through structural measures.
Schimmelpilze
BACTERIA:
Bakterien:
Z.B. E-Coli, Enterobacter, Salmonellen, Klebsiella etc.
E.g. E-coli, Enterobacter, Salmonella, Klebsiella, etc.
Z.B. E-Coli, Enterobacter, Klebsiella etc.





Übertragung durch: Schmierinfektion, tion kontaminierter Aerosole Wischen
Folgen: Gastroenteritis, Konjuktivitis
VIRUSES:

Z.B. Aspergillus, Penicillium
Übertragung durch: Aufgewirbelte sporen, Schimmelpilztoxine
Übertragung durch: Schmierinfektion, Inhalation kontaminierter Aerosole beim Trocknen / Wischen
Transmitted by: Smear infection, inhalation of contaminated aerosols during drying/wiping.
Consequences: Gastroenteritis, conjunctivitis.
Folgen: Gastroenteritis, Konjuktivitis









MOULD:
Schimmelpilze
E.g. Aspergillus, Penicillium.
Z.B. Aspergillus, Penicillium
Transmitted by: Suspended mould spores, mould toxins.
Übertragung durch: Aufgewirbelte Schimmelsporen, Schimmelpilztoxine
Consequences: Allergic reaction to mould spores and mould toxins, organ infestation.
Folgen: Allergische Reaktion auf Schimmelsporen und Schimmelpilzgifte, Organbefall

Folgen: Allergische Reaktion sporen und Schimmelpilzgifte,
E.g. norovirus, rotavirus, or adenovirus.

Z.B. Noro, Rota oder Adenoviren
Übertragung durch: Schmierinfektion, Inhalation kontaminierter Aerosole beim Trocknen / Wischen
Transmitted by: Smear infection, inhalation of contaminated aerosols during drying/ wiping .














Z.B. Candida, Tinea
E.g. Candida, Tinea.
Transmitted by: Contact/smear infection. Consequences: Skin or mucous membrane infections (fungal skin diseases).
Übertragung durch: Kontakt-/ Schmierinfektion
Folgen: Haut– oder Schleimhautinfektionen (Hautpilzerkrankungen)








SD7 for cleaning and disinfection of areas classified as "biological hazard" or biologically related hazard.
Due to its strong disinfection effect and excellent cleaning power, SD7 is ideal for disinfection and cleaning tasks in biologically hazardous areas.
"Biohazard" stands for biological hazard or biological risk area. It refers to biological substances or organisms that pose a threat to human health, animals, or the environment, such as viruses, bacteria, or toxins. The biohazard symbol indicates areas or materials with a biological risk.


Biological hazards may include:
• Microorganisms: Bacteria, viruses, fungi, and parasites that can cause disease.
• Toxins: Poisonous substances that can be secreted by organisms.
• Infectious material: Blood, body fluids, and tissues that may contain infectious organisms.
• Genetically modified organisms (GMOs): Organisms that have been genetically modified and may pose a risk.
SD7 is therefore ideal for use in cleaning and disinfection processes, along with other NAC products, for various biohazard damage restoration tasks. Typical applications include cleaning and disinfection after the discovery of a dead body, severe sewer damage, trauma/accident situations, pest control, urine odour removal, etc.
Other NAC products that can be incorporated into such a process include cleaning, oxidizing, disinfecting, and odour removal chemicals such as Serum 1000, NOVA-OX, EASY-OX, Vaportek odour removal products, Black Max, and Blue Power, as well as our unique cleaning equipment and various other tools.
If you have a challenging project that requires exceptional effort and the use of unique products, don't hesitate to contact NAC Europe. We will send you the process so you can complete your task quickly, safely, and efficiently – with impressive results that your customer will appreciate.









Sanosil 3D Aerosol Disinfection: Here, disinfectant is automatically applied as an ultra-fine mist to the treated area using a fully programmable disinfection system and is used in 3D room disinfection devices: Sanosil Q-Jet C10 (up to 100 m³) or Sanosil Q-Jet CT20 (from 6-600 m³).
Conventional manual spray and wipe disinfection or manual mould removal often only covers an area of 80 mm. This system is used for water and sewer damage, body removal, soot/smoke odour removal, pandemic disinfection (Corona), etc.
Attention: When using professional spraying equipment, aerosols are always produced, which may be harmful. For this reason, you should always wear a full-face respirator when carrying out spraying work to prevent irritation of the respiratory tract and eyes.
Thoroughly clean the surfaces to be treated with a suitable cleaning agent. The better the cleaning, the more effective the disinfection.
Pour the required amount of Sanosil SD7 into the storage tank of a sprayer, e.g. Airofog U260, XPower F-8 og F-16, Tri-Jet 6208 etc. (See bottom of this page). Put on protective equipment (full-face respirator with ABEKP3 filter and gloves).
Select the finest possible atomisation method and spray the surfaces to be disinfected so that a slightly moist surface is created all over them. (Similar to a fogged bathroom mirror when showering.)
Reference value: 30 – 50 ml/m2. Avoid drops/puddles and runs.
Prevent any aerosols (which are inevitably formed when spraying disinfectants) from reaching any parts of the room containing unprotected persons.
Let the product soak in. For safety reasons, no one should enter the room without protective equipment for up to 2 hours after the disinfectant has been sprayed. (Maximum workplace concentration for hydrogen peroxide in the air: 1 ppm)
If the MAC value is too high, increase the waiting time or thoroughly ventilate the room. There must not be any disinfectant odour or irritation of the respiratory tract/eyes.



Note: The finer the droplets, the better the wetting. Avoid drops/puddles and runs caused by applying too much disinfectant. If necessary, wipe the affected areas with a wipe before they dry.

F-8 & F-16



The disinfection method of the future – also within damage restoration
Sanosil 3D aerosol disinfection: disinfectant is automatically blown into the air as an ultra-fine mist using a fully programmable, automatic disinfection machine. This fog disinfects the air, and settles on 100% of all accessible surfaces and disinfects them as well. It is the most modern method of surface disinfection. It closes gaps in the effectiveness of manual surface disinfection/mould cleaning and is establishing itself as an important instrument in the fight against, among other things, antibiotic-resistant bacteria, viruses, moulds and other disease-causing microorganisms.
PS! When remediating mould, 3D room disinfection does not replace the traditional method with a focus on complete cleaning/removal of mould.
1. HEPA vacuuming.
2. Chemical/mechanical removal.
3. Final HEPA vacuuming (just before the final HEPA vacuuming, a 3D room disinfection/odour removal can close gaps in the effectiveness of manual mould cleaning.)

Automatic room fogger
Room size 6-600 m3
Professional mould removal – final disinfection and odour removal
Within mould remediation, Sanosil SD7 can help complete a larger remediation process, where the disinfectant is used for final disinfection of the entire treated area and is used in 3D room disinfection machines: Sanosil Q-Jet C10 (up to 100 m3) or Sanosil Q-Jet CT20 (from 6-600 m3). The traditional manual spray-and-wipe disinfection method or manual mould removal often only achieves 80-90% coverage, which can leave a risky gap in the remediation. We recommend that 3D room disinfection/odour removal be carried out after the mould removal is complete, before a final and thorough HEPA vacuuming of the entire mould-removed area. Furthermore, 3D room disinfection/odour removal can be used for disinfection of rooms and surfaces after water and sewer damage, corpse removal, removal of soot/smoke odour, pandemic disinfection (corona), etc.
1. Residual mould spores in the air are encapsulated and inactivated by the aerosol droplet and carried to the floor.
2. Overlooked residual mould on surfaces is inactivated.
3. Residual odours from the fungi's odorants (MVOCs) are oxidized and eliminated.
4. Minimizes the risk of "failing" the Mycometer test during external control.
5. An extra measure/service that gives happy and confident customers!
6. Doesn't cost much in relation to the effect. For a room size of 40 m3 (approx. 600 ml SD7), the cost is approx. 50 DKK.
7. High quality end result!

Automatic room fogger
Room size 6-100 m3

STEP 2
STEP 1
Note: When transferring SD7 into spray bottles, a label containing information about the contents must be attached to the outside of the container. We can provide suitable labels on request.
Thoroughly clean the surface to be treated with a suitable cleaning agent. The cleaner the surface, the better the disinfection effect.
Put on gloves. Dampen a wipe with undiluted Sanosil SD7.
Dosage on smooth surfaces: 30-50 ml/m2.
Alternative: Use a spray bottle with foam nozzle, apply foam to surface, spread with wipe.

STEP 4

STEP 3
Wet the surface to be disinfected with the cloth so that an even, continuous, moist film remains. Avoid puddles. If drops or puddles remain on smooth surfaces, spread them with the wipe.
Let the agent take effect and dry.

Note: When spraying directly with a device, make every possible effort to avoid aerosol formation. (Use a spray bottle with a foam nozzle.) Suitable respiratory protection must be worn for larger-scale applications (beyond typical household use) in order to avoid irritation of the respiratory tract.



Pressure sprayer for Sanosil
Foam sprayer and regular
pressure sprayer, 1.5 liters.
Sano Wipes are dry wipes in a practical dispenser bucket with a resealable lid. They are soaked in disinfectant before use and are then ready for use for several weeks. Soaked SanoWipes are ideal for the fast intermediate disinfection of smaller surfaces.

STEP 2
STEP 1
Put on gloves. (Basic safety recommendation when handling disinfectants).
Remove the protective film from the wipes roll and place it in the bucket.

STEP 4

STEP 3
Soak the roll with undiluted Sanosil SD7. Dosage 1 - 1.2 liters per roll.
Pull the first wipe through the dispenser opening and close the transparent lid tightly.


MATERIAL PET – optimized for the application of liquids.
WIPES PER ROLL 90 pieces
DIMENSIONS OF THE WIPES 36 x 20 cm

STEP 5
Take out a soaked SanoWipe and thoroughly wipe the surface to be disinfected several times. Wear gloves to avoid skin contact.




ABOUT SANOSIL SD7
Sanosil SD7 is a ready-to-use, fast-acting, surface disinfectant and mould control agent. It is based on a formulation containing enhanced hydrogen peroxide and has excellent wetting properties, even on water-repellent or slightly greasy surfaces. This allows fast and deep penetration even into dense mould structures. When combined with suitable foam sprayers, Sanosil SD7 can be foamed, which allows low-aerosol application with optimised surface coverage.
Low-odour hydrogen peroxide is used as the active ingredient. It is also stabilised and its disinfecting effect is enhanced several times over by adding surfactants. These substances have a synergistic effect and combine with the hydrogen peroxide to form a highly effective biocidal mixture. This combination significantly increases the disinfecting effect of the hydrogen peroxide. After application, the active ingredient, hydrogen peroxide, completely decomposes into water and oxygen. No flammable or unpleasant smelling vapours are released. This makes it safe to use in living rooms and bedrooms.
Moulds can affect health not only due to the allergy-inducing surface proteins on the mycelia and spores, but potentially also through the formation of strong toxins. These mycotoxins are relatively stable and can enter the body through food as well as through the air. Mycotoxins are highly susceptible to SD7 and are quickly oxidised by it. SD7 also denatures the allergenic surface proteins on mould components. This provides SD7 with a special advantage in terms of its effectiveness and makes it superior to many other products.
Sanosil SD7 7,8% hydrogen peroxide cleans organic-based contamination from surfaces through a chemical process called oxidation with an easy-to-use spray and wipe formula.
Bacteria (bactericidal) EN 13727, high load: 5 min EN 17387, high load: 5 min EN 17387, low load: 3 min
Yeast (levurocidal) EN 13624, high load: 5 min EN 17387: 5 min
Fungi EN 13624, high load: 15 min EN 17387, high load: 5 min
Viruses Limited virucidal activity PLUS: EN 14476, high load: 5 min
Spores (clostridium difficile) EN 17126, low load:: 60 min
Good to know:
Limited virucide = Effective against enveloped viruses (e.g. influenza, coronavirus, HIV, Ebola)
Limited virucidal activity PLUS = Effective against enveloped viruses + adenoviruses and noroviruses
Warning! Contact with oxidizable metals may cause discoloration, corrosion is possible with acid-sensitive or non-stainless steel materials. Cover sensitive areas or test the product in a suitable location beforehand.
Safety measures / safe handling: No direct treatment of food and animal feed. Observe standard precautions and skin and eye protection when handling chemicals. When spraying applications with aerosol formation that are larger than normal household areas, the respiratory tract must be protected (mask with protective filter ABEK-P3). See safety data sheet.

Foamable solution for mould cleaning and surface disinfection
APPLICATION AREAS
Excellent wetting effect on all surfaces – the products ability to penetrate semi-porous to porous surfaces like wooden constructions, concrete, plaster and more to deep-clean, loosen and inactivate and remove mould including its roots, is unique to this product. The low surface tension of SD7 allows the product to efficiently, via capillary action, to pull itself into joints and cracks i.e. wooden constructions and more.
STORAGE
The product has a shelf life of at least 24 months without loss of effectiveness. Always store upright in the original packaging and with the original lid. Store cool and away from flammable materials. Once dispensed, do not pour SD7 back into the container. Do not mix with other products. Keep away from flammable materials and chemicals.
Form: Liquid
Colour: Colourless
Viscosity: Ready for processing pH value: 2.8
Weight: approx. 1.01 g/cm3
Composition: 7.8% hydrogen peroxide, 0.05% phenoxyethanol, <1% anionic and non-ionic surfactants.
Packaging: 10 ltr. plastic can
APPLICATION
• Removes surface mould ”bloom” etc.
• Oxidises organic substances.
• Eliminates odours.
• Cleans movables, hard and soft surfaces.
• Do not rinse off the surface.
INSTRUCTIONS FOR USE
Download complete user guide via QR code.
• Ready to use.
• Do not dilute.
• Dries quickly.
• Evaporates 99.9%
• Biodegradable
1. We recommend using Serum 1000 on surfaces with heavy mould growth, where a stronger cleaning agent with greater bleaching effect is needed.
2. For encapsulation of any remaining biomass, spores and particles as well as prevention of mould growth, we recommend Concrobium Protect, which protects with a high Ph value.
CONSUMPTION
1 liter is enough for approx. 15-20 m2 on light mould attacks. 1 liter is enough for approx. 4-8 m2 on moderatesevere mould infestations. The exact consumption is determined by a test application.
COMPATIBILITY WITH OTHER MATERIALS
Sanosil SD7 must not be mixed with other chemistry than Sanosil SFS.
SAFETY
Sanosil SD7 is non-toxic, but can be irritating in the concentration used. Wear suitable protective gloves and goggles/face protection during work. In case of eye contact, rinse immediately with water and seek medical attention. In case of skin contact, rinse the affected areas well with water. White, itchy skin discolorations may appear on these skin surfaces. However, these are harmless and will disappear within a few minutes. Dilute spilled SD7 with water and wipe with a cloth. In addition, refer to the safety data sheet for SD7.
Transport, labeling and disposal
See safety data sheet for Sanosil SD7.
NAC Europe
Ellegårdvej 18 B DK-6400 Sønderborg Tel. +45 7442 6292 Info@nac-europe.com www.nac-europe.com

Warning: Local irritant.
Causes serious eye irritation.(H319). Wear eye protection/face protection.(P280).
IF IN EYES: Rinse continuously with water for several minutes. Remove contact lenses if present and easy to do. Continue rinsing.(P305/351/338).
If eye irritation persists: Get medical advice/attention. (P337/313)
Keep out of reach of children. If swallowed seek medical advice immediately and show this container or label.
Item no.: SD7 Net content: 10 liter
Build a dust barrier in minutes. No ladders, no tape, no damage.

HEPA air purifier for mould spores and more.

LAKELAND
Protective suits for chemicals, mould, and more.

TAPE-GUYS

Double-sided adhesive tape. Air duct protective film.

GREENSPEED

Disposable Microfiber System.


NAC POWERSPRAYER
The best electric sprayers.

HEPA vacuum cleaner for mould remediation.

PROTECTIVE MASKS
Mould, chemicals and more.

RE-U-ZIP
Magnetic entry strip for dust barrier systems.


BIODETECT SYSTEM
Quality control of your mould remediation.


FOAM SPRAYER


Foam-it, Mesto, Birchmeier
HEPA Staubsauger für die Schimmelsanierung.



3-D WHOLE-ROOM DISINFECTION
Sanosil Q-10 and Q-20


MOTORSCRUBBER
Cleaning machine.

Innovative technology for damage restoration – a product with countless applications. SERUM 1000


3IN1


Powerful cleaning/oxidizing agent for removing heavy organic/biological contamination such as mould in homes and buildings.

1. Use safety glasses. Eye protection must comply with EN 166.
2. Use plastic or rubber gloves.
3. Use protective suit type 5-6. When spraying above head height with a risk of splashing/drip, use chemical suit type 3-4.
4. Respiratory protection. A full face mask with a B2/P2 filter must be used for fog spraying.
The NAC Power Sprayer series consists of a number of professional electric sprayers, which deliver extremely good operational reliability and constant pressure with perfect and uniform spray patterns – the electric sprayers are made for the damage service industry.
NAC Power Sprayers never let you down, regardless of whether you use them to apply disinfectants, mould remediation, odour remediation or cleaning agents, etc. At NAC Europe, we know that it is motivating to work with tools that make the work process simple, fast and efficient, thereby creating the best and most profitable results. Because, as is always said:









